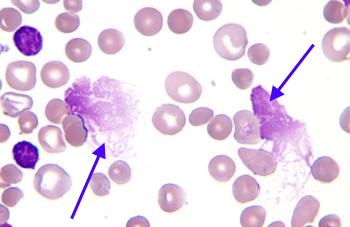
970-174072
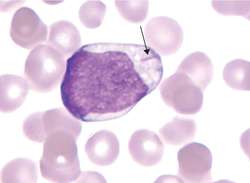
auer-rod

Remember the breakdown and differentiation between AML, ALL, CML, CLL. It starts with understanding the cell line formation:

Nice overview provided by Khan Academy: https://www.khanacademy.org/science/health-and-medicine/hematologic-system-diseases-2/leukemia/v/leukemia-classifications
| Condition | Epidemiology | Clinical Signs/Symptoms | CBC | Morphology | Translocations |
| Acute Lymphoblastic Leukemia (ALL) | Childen (2-5 yo), male > female, association with Downs syndrome | ↓ RBCs, ↓ PMNs, ↓ platelets, +HSM, bone pain, CNS manifestions, tumor lysis syndrome, mediastinal mass | Anemia, thrombocytopenia, variable WBC (>25% lymphobasts) | Condensed chromatin, scant cytoplasm, B cell – CD10+, Tdt+ | t (12;21) kids – good prognosis; t(9;22) – poor prognosis |
| Chronic Lymphoblastic Leukemia (CLL) | Adults Male >>> Female | Asymptomatic or nonspecific, autoimmune hemolytic anemia | Lymphocytosis >5000, low platelets, ↓ antibodies (hypogammaglobulinemia) | Smudge cells, condensed chromatin, scant cytoplasm | |
| Acute Myeloid Leukemia (AML) | Adults > 60 yo (mean 67) | Spontnaeous bleeding, petechiae, ecchymosis, DIC | Anemia, thombocytopenia, >30% myeloblasts | Auer rods, myeloblasts, monoblasts | t (15;17) – APML – treat with ATRA |
| Chronic Myeloid Leukemia (CML) | Ages 20-50; Rare in children | Insidious onset, mild symptoms, splenomegaly | Symptomatic WBC > 200k | Hypercellular marrow | t (9;22) – BCR-ABL – treat with TKI |
Smudge Cells (CLL)
Smudge Cells (CLL)
Auer Rods (AML)
Auer Rods (AML)

One thought on “AM Report 2/21/17: Chronic Myeloid Leukemia”